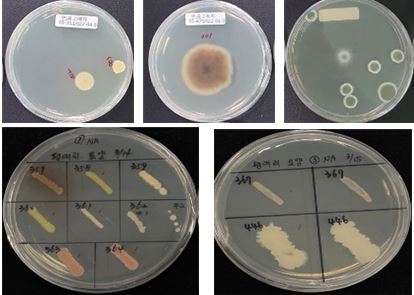

[기계신문] 경기도농업기술원 친환경미생물연구소가 올해부터 5년간 농촌진흥청과 공동으로 ‘배추과(科) 뿌리혹병 방제를 위한 유용 미생물과 친환경 활용 기술 개발 연구’를 진행한다고 14일 밝혔다.
뿌리혹병은 토양 전염성 병원균으로 배추, 양배추, 무 등 십자화과 식물은 모두 감염될 수 있고, 이 병이 발생할 경우 수확량이 최대 80%까지 줄어들 수 있다. 한 번 병원균이 발생하면 완전한 방제가 어렵고, 최대 10년간 토양에 남아 계속 피해를 주기 때문에 사전 대응이 중요하다.
농기원 친환경미생물연구소는 최근 표고버섯 수확 후 배지(培地), 뿌리혹병 발병지 내 건전한 식물체의 뿌리 부분, 기존 유전자원 등에서 유익한 미생물 111균주(菌株)를 확보했다.
항생 물질을 분비하는 곰팡이 페니실리움 속(Penicillium sp.)과 세균류인 바실러스 속(Bacillus sp.) 등이다. 이 미생물들은 균 세포막을 분해시키는 방식으로 작물 내 뿌리혹병원균을 절반 이상 사멸시킬 수 있다.
이와 함께 연구소는 유용 미생물의 원활한 증식과 탄소중립 기여를 위해 표면적이 큰 탄소 저감형 유기농업 자재에 미생물을 결합시키는 기술도 함께 개발 중이다. 이 기술을 활용하면 농가에서 환경친화적으로 뿌리혹병을 관리하며 안정적으로 농산물을 생산할 수 있을 것으로 기대된다.
농기원은 올해 기술 개발 진행 상황에 따라 내년 방제 기능 미생물 배양 방법 개발, 배추 재배 농가 현장 실증 등 후속 연구를 이어나갈 예정이다.
임갑준 경기도농업기술원 친환경미생물연구소장은 “농가들이 병해충으로 어려움을 겪고 있는 작목에 대해 친환경 방제 기술을 지속적으로 개발해 소비 증대와 좋은 먹거리 공급으로 이어질 수 있도록 노력하겠다”고 말했다.
기계신문, 기계산업 뉴스채널

